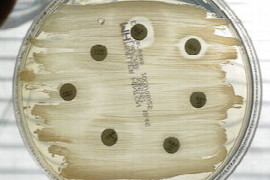

Ingrid Allgoewer
DVM, DECVO

Ingrid Allgoewer
DVM, DECVO
Dr. Ingrid Allgoewer Diplomate European College of Veterinary Ophthalmologists Nach dem Studium der Tiermedizin in München und Hannover Promotion an der Ludwig-Maximilians-Universität (LMU) München. Anschliessend 10 Jahre wissenschaftliche Assistenz an der Chirurgischen Tierklinik der LMU München und der Kleintierklinik der FU Berlin. Im Jahr 2000 Gründung der Augen-Tierarztpraxis Dr. Allgoewer in Berlin. Zahlreiche Publikationen, Vorträge, Seminare, Mikrochirurgiekurse, Koautorin (Slatters Fundamentals in Ophthalmology 6th ed), Diplomate of the European College of Veterinary Ophthalmologists (ECVO), ECVO Vorstandsmitglied 2000-2014, Präsidentin des ECVO 2010-2012, Diplomate Colegio Latinoamericano de Oftalmólogos Veterinarios (CLOVE), Mitglied des Dortmunder Kreis (DOK), Vorsitzende des Prüfungsausschusses des DOK
Webinare

Ingrid Lorenz
DVM, PD, Dipl. ECBHM

Ingrid Lorenz
DVM, PD, Dipl. ECBHM
Dr. Lorenz absolvierte ihr veterinärmedizinisches Studium an der Ludwig-Maximilians-Universität in München. Nach der Approbation 1992 begann sie ein Promotionsstudium an der Klinik für Wiederkäuer der Universität München, das sie 1997 erfolgreich abschloss.
Von 1996 bis 2007 arbeitete sie als Wissenschaftliche Mitarbeiterin/Akad. Rätin a. Zeit an der Klinik für Wiederkäuer. 2007 habilitierte sie sich dort zu dem Thema „Die Bedeutung der D-Laktatazidose bei Kälbern mit Neugeborenendurchfall“.
Bevor sie im März nach Bayern zurückkam, um ihre jetzige Position als Leiterin des Rindergesundheitsdienstes beim Tiergesundheitsdienst Bayern anzutreten, hat sie für neun Jahre die Rindermedizin in Lehre, Forschung und Dienstleistung an der Tierärztlichen Fakultät der Universität Dublin, Irland vertreten.
Ihre Forschungsschwerpunkte sind die metabolischen Veränderungen bei Kälberdurchfall, sowie die Kälbergesundheit auf Bestandesebene.
Webinare

Irene Bruckner
DVM, Fachtierärztin für Ernährung und Diätetik

Irene Bruckner
DVM, Fachtierärztin für Ernährung und Diätetik
Studium und Promotion an der Vetmeduni Vienna
Arbeit in verschiedenen Kleintierpraxen und Tierschutzprojekten
Leitung internationaler Streunertier- Hilfsprojekte
Seit 2008 bei Royal Canin im Bereich Diätetik und Fortbildungen tätig
Webinare

Irene Summer
DVM

Irene Summer
DVM
Mag. Irene Summer arbeitete nach ihrem Veterinärmedizinstudium in Wien als Tierärztin in privaten Kleintierpraxen und hat 2012 das Rotating Internship der Kleintiermedizin an der Veterinärmedizinischen Universität Wien absolviert.
Während dieser Zeit hat sie auch im Departement für Zahnheilkunde und Kieferchirurgie unter Dr. Matthias Schweda assistiert und dabei die Liebe zur Zahnheilkunde entdeckt.
Danach hat sie sich immer mehr auf Zahnheilkunde und Kieferchirurgie konzentriert und Aus- & Weiterbildungen in diesem Bereich absolviert, unter anderem 2016 ESAVS Veterinary Dentistry und 2019 Interaktives Zahn-Kompakt Seminar von Dr. Matthias Schweda, bei dem sie regelmäßig, in Form von Praktika, ihr Wissen erweitert.
2019 hat Irene ihre Tätigkeit in der KATZENPRAXIS begonnen und leitet hier den Bereich Zahnheilkunde und Kieferchirurgie sowie Allgemeinchirurgie.
2020 hat sie erfolgreich DentalVet gegründet, die mobile Betreuung von Zahnpatienten in Kooperation mit Kleintierpraxen.
Der nächste Schritt ist die Absolvierung des ÖTK Diploms für Zahn-und Kieferheilkunde.
Webinare

Isabelle Iff
DVM, Dip.ECVAA, CertVetAc(IVAS)

Isabelle Iff
DVM, Dip.ECVAA, CertVetAc(IVAS)
Isabelle received her veterinary diploma from the Vetsuisse Faculty at the University of Bern and completed a rotating internship at the Animal Hospital Bern. She was particularly interested in anaesthesia, pain therapy and intensive care medicine. She then began her residency at the Department of Anaesthesiology at the Animal Hospital Bern. She received her doctorate with a dissertation on the subject about epidural anaesthesia in dogs. She moved to Vienna, completed her residency and has been a diplomat at the European College of Veterinary Anaesthesia and Analgesia since 2006. She deepened her interest in pain therapy with an education in animal acupuncture. Between 2007 and 2010 she worked as a Senior Clinical Anaesthetist at the Animal Hospital of the University of Liverpool (UK). She established the Pain Clinic for Small Animals at the Animal Hospital and completed additional training in acupuncture. She then worked as a representative in England and Canada and from 2011 to 2016 she worked for Veterinary Anaesthesia Services in Winterthur, where she started a pain consultation in collaboration with the Zurich Animal Hospital. She has trained in osteopathy and since 2017 Isabelle has been working part-time at the University of Bern in anaesthesiology and founded her own company vet doc iff gmbh (www.vet-doc-iff.ch), where she offers pain therapy and complementary medicine for small animals.
Webinare

Isabelle Iff
DVM

Isabelle Iff
DVM
Isabelle a obtenu son diplôme de vétérinaire à la Faculté de l’Université de Berne et a complété un « internship » à l’hôpital pour les petits animaux de Berne. Elle a suivi une formation spéciale au département d’anesthésiologie à l’hôpital vétérinaire de Berne. Elle s’est ensuite installée à Vienne où elle a terminé sa formation. En 2006 elle a obtenu le titre de Spécialiste de l’anesthésie et analgésie vétérinaire, « Diploma of the European College of Veterinary Anaesthesia and Analgesia ». Entre 2007 et 2010, elle a travaillé comme «Chef anesthésiste“ à l’hôpital vétérinaire de l’Université de Liverpool (Royaume-Uni). Elle y a créé la clinique de la douleur pour les petits animaux et a suivi une formation complémentaire en acupuncture. Elle a fait des remplacements notamment dans un grand hôpital de référence (Solihull, Royaume-Uni) et au Collège Vétérinaire de l’Atlantique (Canada) et a travaillé à VAS de 2011-2016. En collaboration avec l’anesthésie de l’hôpital des petits animaux de Zürich elle a établi des consultations pour la douleur chronique. Depuis 2017 elle travaille à l’Université de Berne comme cheffe de clinique dans l’anesthésie de la faculté Vetsuisse à temps partiel. En parallèle, elle travaille également pour son propre cabinet (vet doc iff gmbh).
Webinare

Isabelle Resch
DVM, BVSc, MVS, MANZCVS (Small Animal Medicine, Vet Behaviour)

Isabelle Resch
DVM, BVSc, MVS, MANZCVS (Small Animal Medicine, Vet Behaviour)
Isabelle graduated from the University of Sydney and has worked in small animal practice since then. She completed a Master of Veterinary Studies and Membership in Small Animal Medicine in 2001. Isabelle passed her Membership examinations in Veterinary Behaviour in 2016 and is currently undertaking a residency in Behavioural Medicine with the Australian and New Zealand College of Veterinary Scientists and the American College of Veterinary Behaviour, on the pathway to becoming a Veterinary Behavioural Medicine specialist.
Isabelle is a tutor for the Distance Education programme in Veterinary Behaviour, University of Sydney, a consultant for the Veterinary Information Network (VIN) in Behaviour and has been an examiner for the Australia New Zealand College of Veterinary Scientists. She is the current President of AVBM (Australian Veterinary Behavioural Medicine), a special interest group of the Australian Veterinary Association (AVA).
She attends several national and international behaviour conferences every year and is passionate about providing ongoing education to help to continue growing and developing the field of veterinary behaviour. She currently works at Canberra Animal Behaviour Solutions at the Animal Referral Hospital in Canberra.
Webinare

Ivo Schmerold
Univ.Prof. DVM

Ivo Schmerold
Univ.Prof. DVM
Akademischer Werdegang
- Studium der Veterinärmedizin 1970 - 75, Ludwig-Maximilians-Universität München
- Dissertation, 1978, Ludwig-Maximilians-Universität München
- Fachtierarzt für Pharmakologie und Toxikologie (Bayerische Tierärztekammer), 1984
- Habilitation, 1991, Fach Pharmakologie und Toxikologie, Veterinärmedizinische Fakultät, Ludwig-Maximilians-Universität München
Beruflicher Werdegang
- Wissenschaftlicher Assistent, 1978 – 91, Anstellung an verschiedenen Universitäten (München, Freiburg i.Br., Zürich, Purdue University, West-Lafayette, IN, USA.)
- Wissenschaftlicher Angestellter, 1991 – 94, Bundesgesundheitsamt in Berlin, Institut für Veterinärmedizin, Leiter der Einheit „Toxikologie“
- Professor für Pharmakologie, ab 1995, Institut für Pharmakologie und Toxikologie, Veterinärmedizinische Universität Wien; 2001 - 2010 Leitung des Instituts, Ruhestand seit Aug. 2012
Webinare

Jack Davey
DVM

Jack Davey
DVM
Jack graduated from Charles Sturt University, Wagga Wagga, with first class Honours for his research on bone healing and also received the ‘Bruce Christie Surgical Prize’ for a high level of aptitude and clinical skills in small animal surgery during the veterinary course.
He then started his career as a veterinarian working in Launceston, Tasmania as a mixed animal veterinarian where his passion for surgery strengthened. In 2018, Jack was awarded the NVC’s ‘Best Recent Graduate’ award for his work in veterinary clinics across Tasmania, Victoria and South Australia with both large and small animals.
Now with the aim to further his surgical skills, Jack is undertaking a residency in Small Animal Surgery at ARH Canberra.
Webinare

Jackie Campbell
DVM, BVSc Hons, Dip CMT, CHPV

Jackie Campbell
DVM, BVSc Hons, Dip CMT, CHPV
Jackie is one of Australia’s leading voices in the field of veterinary palliative care. The owner of Sunset Vets, the nation’s largest network of veterinarians focused exclusively on palliative and end-of-life support services, Jackie spends much of her time helping families to effectively navigate medical decision making at end-of-life.
After graduating with honours from the University of Queensland in 2006 Jackie quickly became a passionate advocate for the advancement of palliative medicine within the veterinary field. In 2017 she became Australia’s first veterinarian to achieve certification in Animal Hospice and Palliative Care (CHPV). She holds a diploma in Canine Myofunctional Therapy and has clinical interests in osteoarthritis and chronic pain, making her a vocal supporter for the inclusion of allied health and interdisciplinary professionals within veterinary treatment plans.
Webinare

Jaclyn Gatt
DVM, BVSc, MVS (Cons Med), MANZCVS (Unusual Pets)

Jaclyn Gatt
DVM, BVSc, MVS (Cons Med), MANZCVS (Unusual Pets)
Jaclyn graduated from Melbourne University in 2010 and worked for almost 5 years in one of Melbourne’s busiest hospitals as a small animal and exotic pet vet. She spent 3 years working in emergency and critical care before opening the Bird & Exotic Animal Clinic with Dr Glynn Lam in 2016.
In 2015 Jaclyn completed a Masters of Veterinary Studies in Conservation Medicine through Murdoch University, covering a wide range of species including those commonly kept as pets, along with zoo animals and wildlife. Jaclyn obtained Memberships in Medicine and Surgery of Unusual Pets in 2019 and sees a large number of primary and referral exotic cases. Her favourite topics include emergency and critical care of exotic pets, rabbit dentistry and soft tissue surgery. She is very excited to be given an opportunity to share her passion for exotics and their unique medical challenges in this webinar.
Webinare

Jacob Michelsen
DVM, BVSc(Hons), BSc(Vet)(Hons), MACVSc, GC(Management), DACVS Management, Diplomat of the American College of Veterinary Surgeons (SA)

Jacob Michelsen
DVM, BVSc(Hons), BSc(Vet)(Hons), MACVSc, GC(Management), DACVS Management, Diplomat of the American College of Veterinary Surgeons (SA)
Jacob graduated from Sydney University in 1990 and worked in mixed practice for two years before buying his own practice in South West Sydney with his wife and fellow veterinarian. The practice grew to become a group of practices and after 15 years were sold when Jacob and his family moved to Denmark. In 2008 A surgical residency at Charles Sturt University enticed him back to Australia. During his residency Jacob was fortunate enough to secure externships at Utrecht University under Prof. Jolle Kirpenstein, at North Carolina State University and with Charles Kuntz at South Paws in Melbourne. Jacob passed his Board exams in 2013 and moved to Canberra in 2014 to take up a surgical specialty and practice management position at ARH Canberra.
Webinare

Jacqui Ley
BVSc (Hons), FANZCVS (Animal Behaviour), CMAVA PhD

Jacqui Ley
BVSc (Hons), FANZCVS (Animal Behaviour), CMAVA PhD
Jacqui Ley is a registered specialist in Behavioural Medicine. She graduated from Melbourne University Veterinary School in 1995. A long time interest in animals, animal behaviour and training led her to undertake a Membership to the ACVSc in Veterinary Behaviour in 2000. Looking to understand more about behaviour, she left small animal practice for the world of research and investigated tests for measuring fear in dogs. Jacqui has completed a PhD at Monash University developing a model and questionnaire for describing canine personality.
Webinare

James Rushton
DVM, PhD, MRCVS

James Rushton
DVM, PhD, MRCVS
James Rushton beendete 2009 sein Studium an der Vetmeduni Wien und schloss ein Rotating Internship Pferdemedizin an. Seit 2010 ist er an der Augenstation der Vetmeduni Wien tätig. Nach dem Abschluss seines PhDs begann er eine 3 jähriges Residency Programm im European College of Veterinary Ophthalmology.
Webinare

James Simcock
BVSc (hons), MACVSc (Internal Med), Diplomate ACVS

James Simcock
BVSc (hons), MACVSc (Internal Med), Diplomate ACVS
James graduated from the University of Melbourne with honors in 2005. Following graduation he worked for 12 months in a busy small animal general practice.
In 2010 James achieved membership to the Australian College of Veterinary Scientists Internal Medicine Chapter. In 2013 he became a Diplomate of the American College of Veterinary Surgeons by passing the certification examinations on his first attempt.